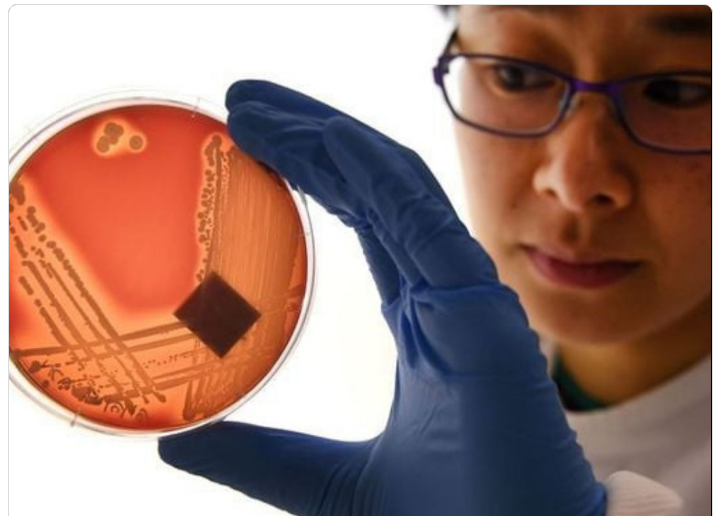

A Organização Mundial da Saúde (OMS) acendeu um alerta global: se o uso inadequado de antibióticos continuar crescendo, a resistência antimicrobiana poderá causar até 10 milhões de mortes anuais até 2050, ultrapassando o câncer como principal causa de óbito no mundo. Hoje, mais de 1,27 milhão de pessoas morrem todos os anos em decorrência de infecções causadas por bactérias resistentes.